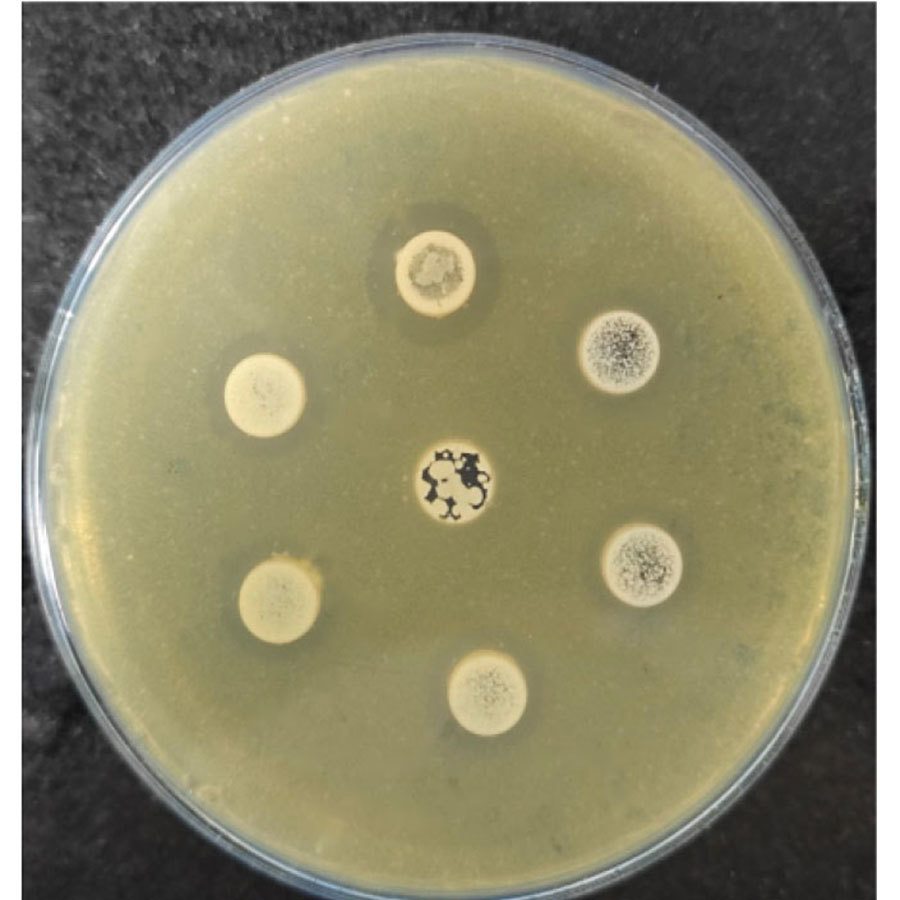
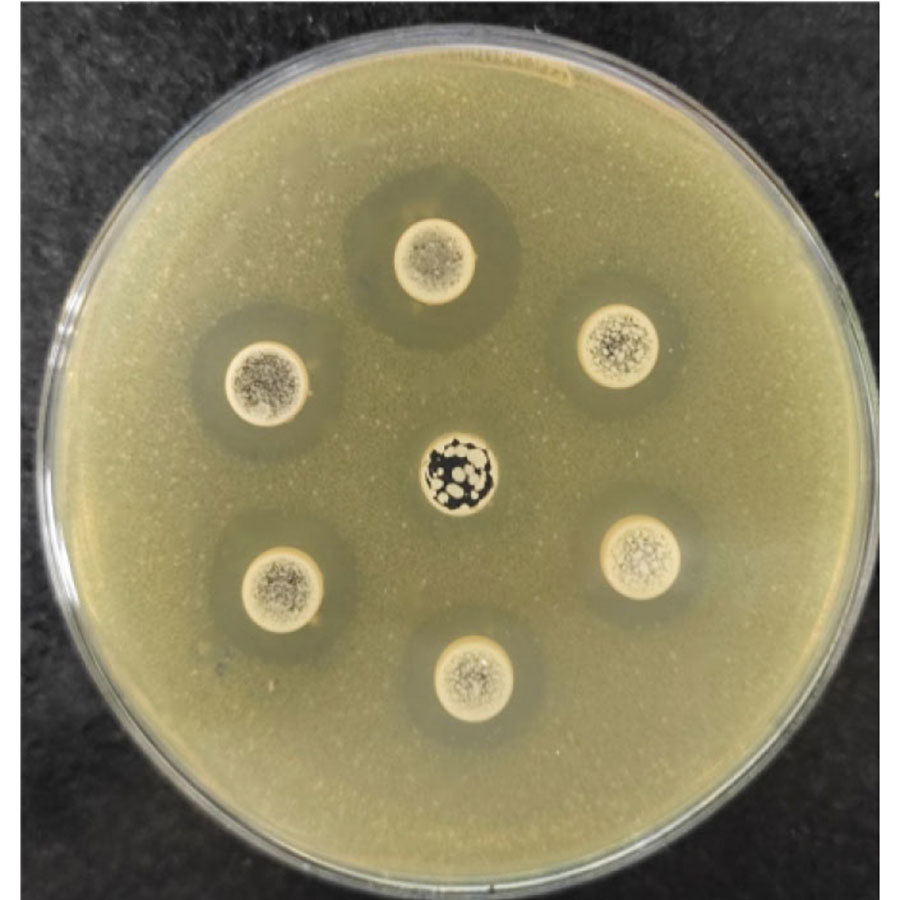

産氣英膜梭菌抑菌圈

酵母培養物(wù)-沃豐寶
酵母培養物(wù)沃豐寶是(shì)一(yī)款适用(yòng)于反刍動物(w♣♥≥ù),富含營養活性物(wù)質的(de)δ♣酵母培養物(wù)。
酵母培養物(wù)-沃豐寶
産品介紹
酵母培養物(wù)沃豐寶是(shì)一(yī)款适用(yòng)于反±↕€刍動物(wù),富含營養活性物(wù)質的(de)酵母培養物(wù)。本産₩→品優選特異菌株,采用(yòng)農(nóng)業(yè)農(n♠€™♥óng)村(cūn)部飼料工(gōng)業(yè)₽↕中心與沃豐德聯合研發工(gōng)藝,經液态純培養和(hé)固♦≥态培養兩段式發酵而成。産品富含有(yǒu)抑殺革®$±✘蘭氏陽性和(hé)陰性菌的(de)功能(néng)性小(xiǎo)肽、有(yǒ< ®u)機(jī)酸、B組維生(shēng)素及酵∏↑母代謝(xiè)因子(zǐ)等多(duō)種活性物(wù)質,可δ∑☆(kě)在飼料及養殖端使用(yòng),具有(yǒu)增加π↑€采食量、改善消化(huà)率、提高(gāo ×&λ)生(shēng)産性能(néng)、預防乳房(fáng)炎、降低(d★ δ ī)犢牛腹瀉率等功效。
産品功效
۞ 增加采食量
۞ 提高(gāo)生(shēng)産性能(néng)
۞ 預防乳房(fáng)炎
۞ 改善消化(huà)率和(hé)提高(gāo)飼料利用(yòng)率
۞ 促進犢牛瘤胃發育、降低(dī)犢牛腹瀉率
産品成分(fēn)分(fēn)析保證值
粗蛋白(bái)≥15%,甘露聚糖≥0.5γ''π%,粗灰分(fēn)≤8%,水(shuǐ)分♥£♠(fēn)≤12%
産品機(jī)理(lǐ)
酵母培養物(wù)沃豐寶優選的(de£¥§)特異菌株,發酵适應強,采用(yòng)特殊的(de)₽♣♦"發酵工(gōng)藝獲得(de)多(duō)種活性成↕"₽分(fēn),可(kě)為(wèi)瘤胃微(wēi)生 λ(shēng)物(wù)生(shēng)長(cháng)增值提供充♥<γσ足的(de)營養底物(wù),促進其生(shēng)産繁γ∑₩殖;另外(wài),發酵過程中可(kě)保持較高(gāo)的(<β€Ωde)功能(néng)性活性成分(fēn),低(dī)溫快(ku$≥₹ ài)速幹燥可(kě)保持成品中較高(gāo)的(de)生(shēng)ε↕®"物(wù)活性,可(kě)抑殺瘤胃中有(y α&ǒu)害微(wēi)生(shēng)物(wù)的(de×€)生(shēng)長(cháng)繁殖,調節瘤胃菌群平衡,有(y♥ǒu)效促進纖維分(fēn)解菌增值,預防瘤胃酸中毒,調節瘤胃健康∏≠≠,提升飼料轉化(huà)效率。
在奶牛生(shēng)産上(shàng)的(de)應用(yòng)
飼喂酵母培養物(wù)在泌乳奶牛上(shàng)的(de)應用(yòδ£☆ng)效果評價
試驗選擇經産健康泌乳後期荷斯坦奶牛100頭,胎¶¥♣次(2.73±0.74)、産奶量(39.94∑↕土(tǔ)6.98 kg/d)、泌乳天數(shù)(201.08±10.86)Ωσ相(xiàng)近(jìn)。采用(yòng)散欄飼養,每天飼喂✘≤&三次,自(zì)由飲水(shuǐ),擠奶3次。
預試期10天,正試期60天。
注:YC組,n=50(酵母培養物(wù)125 g/d/cow) •$ ≈Ω CON(對(duì)照(zhào)組),n=50δ©←(酵母培養物(wù)0g/d/cow)
圖 飼喂酵母培養物(wù)對(duì)泌乳奶牛産奶量、DMI的(↕↕de)影(yǐng)響(n=100)
圖 飼喂酵母培養物(wù)對(duì)泌乳奶牛飼料效率↔β±的(de)影(yǐng)響(n=100)
圖 飼喂酵母培養物(wù)對(duì)泌乳奶牛養分(fēn)表觀消化←♥∏γ(huà)率的(de)影(yǐng)響
表 日(rì)糧中添加酵母培養物(wù)對(duì)奶牛生(shē¶ ©ng)産性能(néng)的(de)影(yǐng)響
項目 | 組别 Group | SEM | P-value | |
ltems | CON | YC | ||
乳脂率 Milk fat/% | 5.25a | 4.76b | 0.10 | 0.02 |
乳蛋白(bái)率 Milkprotein% | 3.56 | 3.43 | 0.04 | 0.06 |
乳糖率 Milk lactose/% | 5.08a | 5.19b | 0.02 | 0.01 |
乳脂産量Fat yield,kg/d | 1.85a | 1.76b | 0.02 | 0.01 |
乳蛋白(bái)産量Protein yie←¶≤ld,kg/d | 1.26 | 1.27 | 0.01 | 0.55 |
乳糖産量Lactose yield,kg/d | 1.80a | 1.92b | 0.02 | 0.00 |
體(tǐ)細胞數(shù)SCC/(×104/mL) | 114.20a | 53.20b | 10.44 | 0.00 |
表 日(rì)糧中添加酵母培養物(wù)對(du₩♠™™ì)奶牛瘤冒發酵的(de)影(yǐng)響
飼喂酵母培養物(wù)後:
۞ 在生(shēng)産性能(néng)上(± shàng),能(néng)夠提高(gāo)泌乳γ¥ ₹奶牛乳脂率、乳糖率及乳脂、乳糖産量,改善乳成分(fēn);顯著降低 ☆(dī)乳體(tǐ)細胞數(shù)目,從(↕"cóng)而起到(dào)預防隐性乳房(fáng)炎↓§×的(de)作(zuò)用(yòng);
۞ 在奶牛瘤胃發酵上(shàng),能(néng)夠促進乙酸、丁酸和(hé)TVFσ♠A的(de)合成,增加瘤胃發酵;提高(gāo)丙←&酸含量從(cóng)而促進乳糖的(de)合成,提高(gāo)産奶量;
۞ 在氮利用(yòng)上(shàng),加速降解NH3-N,促進 >↓☆MCP的(de)合成,從(cóng)而提高(gāo)氮♣≤≠的(de)利用(yòng)率。
體(tǐ)外(wài)抑菌試驗:對(du✔ε©ì)産氣英膜梭菌、大(dà)腸杆菌、沙門(mén)氏菌γ §等有(yǒu)害菌有(yǒu)顯著的(de)抑殺作(zuò)用(yòn₽®β¥g)。
用(yòng)法用(yòng)量
使用(yòng)說(shuō)明(míng):→♦精補料3-5kg/t
包裝保藏:20kg/袋,牛皮紙(zhǐ)袋包裝;通(tōng)風("≈φfēng)幹燥處儲存,保質期18個(gè)月(yuè)。
注意事(shì)項:啓封後盡快(kuài)使用(yòng),用(yò× ng)後應密封,注意防潮。
Category:
Keyword:
相(xiàng)關産品